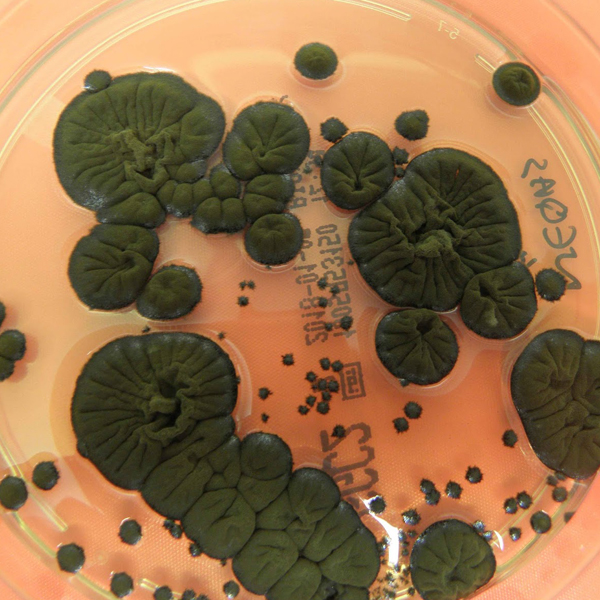

Exhibition Meditates Upon How Women and Nature Converge Through Painting and Sculpture
If nothing else, literature, myths, folklore, and art history have taught us that the female body and the Earth itself are often thematically compatible. In her latest solo exhibition, De Tierra y Susurros, Hilda Palafox continues this line of inquiry, but through a distinctly Latin American lens. Now open at Sean Kelly Gallery in New York, the show gathers several paintings and sculptural reliefs that consider femininity and its relationship to nature.